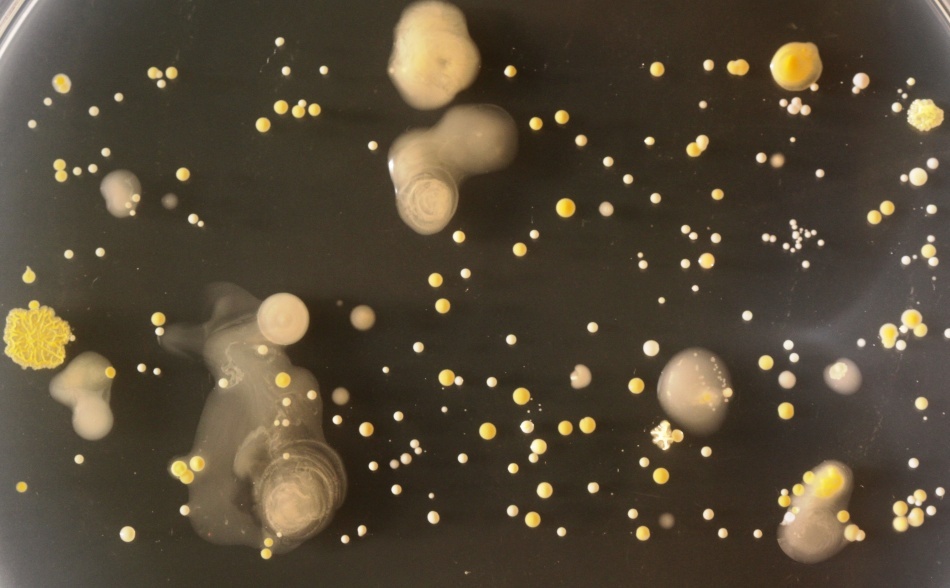
Bacteriile găsite pe telefoanele mobile/ Foto credit: Simon Park, Univeristatea Surrey
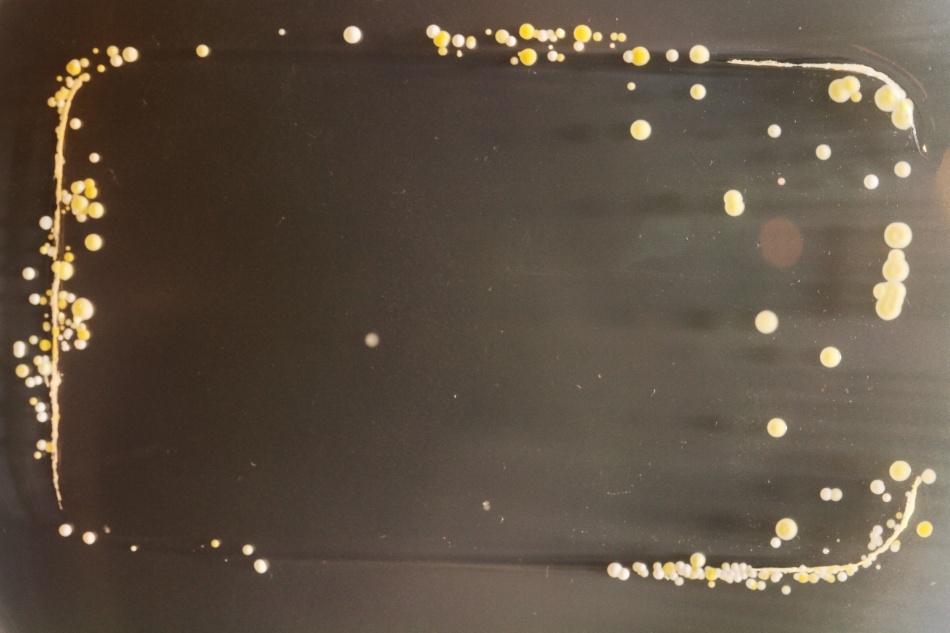
Bacteriile găsite pe telefoanele mobile/ Foto credit: Simon Park, Univeristatea Surrey
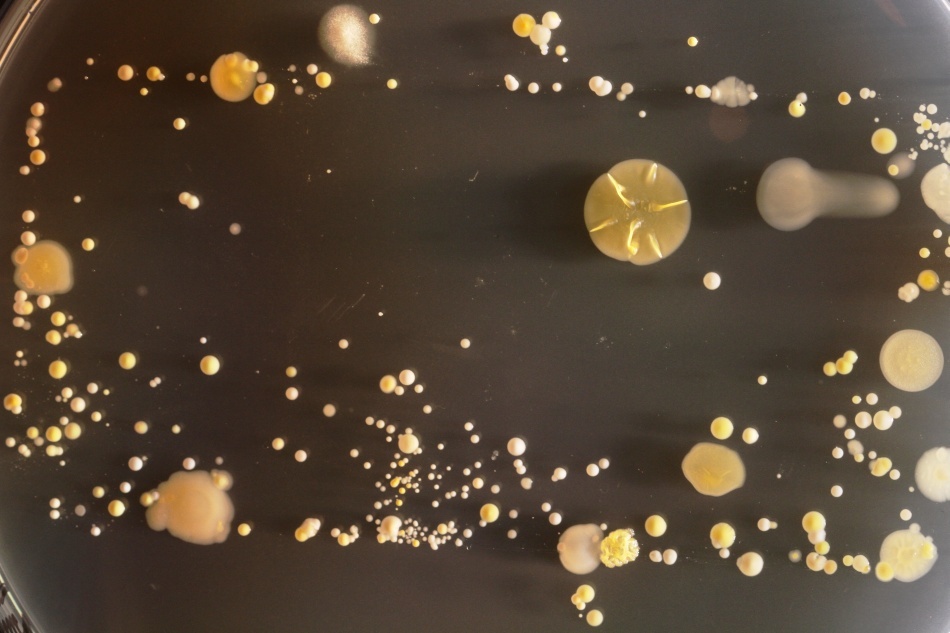
Bacteriile găsite pe telefoanele mobile/ Foto credit: Simon Park, Univeristatea Surrey
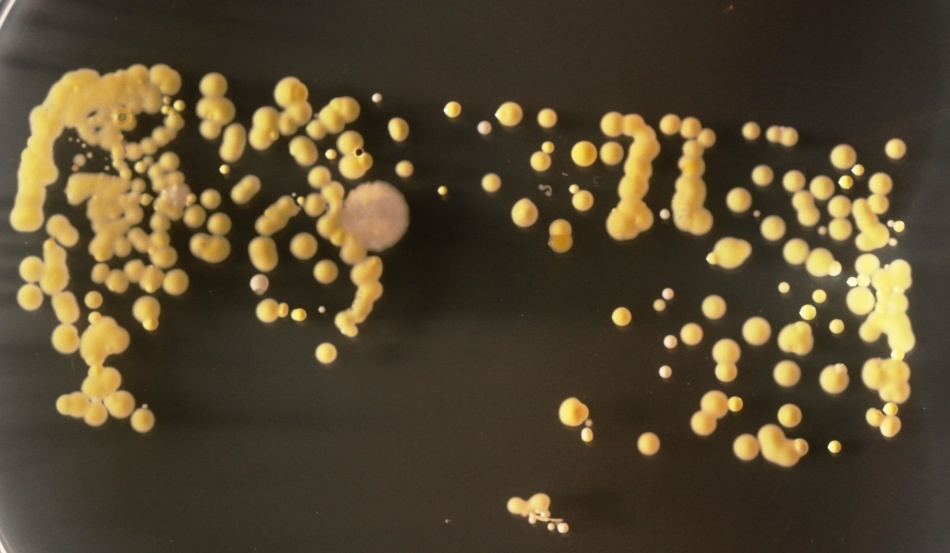
Bacteriile găsite pe telefoanele mobile/ Foto credit: Simon Park, Univeristatea Surrey

Studenţii îndrumaţi de profesorul Simon Park au fost încurajaţi să îşi aşeze telefoanele pe mediul de cultură din plăcile petri astfel încât să poată identifica bacteriile de pe ecranele dispozitivelor. După trei zile, pe mediul de cultură au proliferat bacterii.
Potrivit lui Park, majoritatea bacteriilor găsite aici erau inofensive, făcând parte dintre acele organisme care se găsesc pe piele. Cu toate acestea, se pare că de pe ecranele telefoanelor mobile nu lipsesc nici bacteriile purtătoare de boli, precum streptococul auriu .
Având în vedere că aproximativ 20% din populaţia actuală este purtătoarea acestei bacterii, în timp ce 60% dintre noi suntem purtători intermitenţi, Park spune că descoperirea nu ar trebui să ne mire.
„Nişa ecologică (locul pe unde pătrunde) streptococul auriu sunt nările. Prin urmare, dacă te apuci să scri un mesaj după ce ai băgat degetul în nas, te alegi cu un patogen pe telefonul mobil”, a explicat Park.

Aceasta este imaginea preferată a lui Park. „Poţi vedea clar conturul telefonului, dar toată placa este acoperită de o bacterie numită Bacillus mycoides. Acest model de creştere este unic şi pentru că ştim că mediul natural al bacteriei este solul, ştim că fie telefonul a intrat în contact direct sau indirect (prin intermediul utilizatorului), cu solul. Fiecare telefon spune o poveste!”, a explicat Park.
Acum, înainte de a vă grăbi s vă dezinfectaţi telefonul aruncaţi o privire peste spectaculoasele imagini de mai jos.

Surse: Wired, Exploring the Invisible